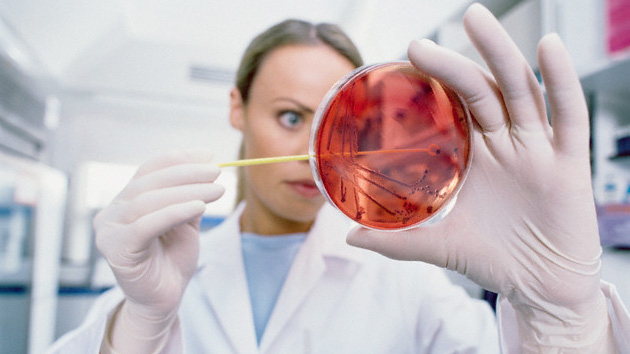
Japón alerta sobre brote de virus mortal

Japón alerta sobre brote de virus mortal
[Tokio.- El Ministerio de Sanidad de Japón anunció la detección del primer caso en el mundo de contagio del virus SFTS a humanos por otros mamíferos, registrado en una mujer que murió tras contraer esta rara enfermedad al ser mordida por un gato.
La mujer falleció el año pasado a causa del SFTSV (siglas de Bunyavirus del Síndrome de Fiebre Grave con Trombocitopenia), un virus identificado por primera vez en China en 2010 y cuyos primeros contagios se registraron en Japón en 2013.
Hasta ahora se han registrado 266 infecciones de SFTS en humanos en Japón, de los cuales 57 han muerto, mientras que en China se han dado varios centenares de casos, principalmente en el centro y el noreste del país, y en Corea del Sur se han detectado también varias decenas de contagios.
Los principales síntomas que provoca son fiebre, trombocitopenia, problemas gastrointestinales y leucopenia, y su mortalidad se sitúa entre el 12 y el 30 por ciento de los casos, lo que supone un nivel inusualmente alto.(Agencias)]
La mujer falleció el año pasado a causa del SFTSV (siglas de Bunyavirus del Síndrome de Fiebre Grave con Trombocitopenia), un virus identificado por primera vez en China en 2010 y cuyos primeros contagios se registraron en Japón en 2013.
Hasta ahora se han registrado 266 infecciones de SFTS en humanos en Japón, de los cuales 57 han muerto, mientras que en China se han dado varios centenares de casos, principalmente en el centro y el noreste del país, y en Corea del Sur se han detectado también varias decenas de contagios.
Los principales síntomas que provoca son fiebre, trombocitopenia, problemas gastrointestinales y leucopenia, y su mortalidad se sitúa entre el 12 y el 30 por ciento de los casos, lo que supone un nivel inusualmente alto.(Agencias)]
Share












En… Redes Sociales